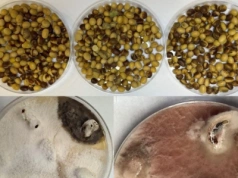
Groźne grzyby mogą być ukryte w nasionach soi! Osłabione wschody i plonowanie

sport.pl
Polski faworyt do medalu przemówił. To jego przepis na sukces
Polski faworyt do medalu przemówił. To jego przepis na sukces
60 polskich sportowców rywalizuje we Włoszech podczas Zimowych Igrzysk Olimpijskich Mediolan-Cortina 2026. Najpoważniejszym kandydatem do zdobycia medalu jest panczenista Damian Żurek, który ma za sobą bardzo dobry sezon. Po sobotnich treningach zdra...
sport.pl,
2026-02-07 20:13:06
2026-02-07 20:13:06

medonet.pl
Janek pracuje w pogotowiu. "Gdy zobaczyłem skalę stosowania tych leków, byłem przerażony"
Janek pracuje w pogotowiu. "Gdy zobaczyłem skalę stosowania tych leków, byłem przerażony"
— Przyznam szczerze, że gdy zobaczyłem skalę stosowania tych leków, byłem przerażony. To szokujące, ile osób w podeszłym wieku pokazuje mi blister z benzodiazepinami i mówi, że to na ból pleców albo gorszy dzień. A gdy pytam, ile pani tego bierze, mó...
medonet.pl,
2026-02-07 20:12:08
2026-02-07 20:12:08

plotek.pl
Król Karol III ma surowe zasady. Tego nie można robić w pałacowej kuchni
Król Karol III ma surowe zasady. Tego nie można robić w pałacowej kuchni
Nie jest tajemnicą, że król Karol ma szczególne upodobania jedzeniowe. Oprócz ulubionych potraw ma też jedną zasadę, która musi być egzekwowana w pałacowej kuchni.
plotek.pl,
2026-02-07 20:12:04
2026-02-07 20:12:04

polsatsport.pl
Finał dla siatkarek BKS. Ambitna postawa pierwszoligowca
Finał dla siatkarek BKS. Ambitna postawa pierwszoligowca
Siatkarki Netland MKS Kalisz przegrały z BKS Bostik ZGO Bielsko-Biała 0:3 w rozegranym w Elblągu półfinale Tauron Pucharu Polski siatkarek. Pierwszoligowa drużyna z Kalisza, mimo ambitnej postawy, nie zdołała zagrozić ekipie z Tauron Ligi. W niedziel...
polsatsport.pl,
2026-02-07 20:11:06
2026-02-07 20:11:06

newsnadzis.pl
Awaria ciepła na Ursynowie i Mokotowie. Kiedy ogrzewanie wróci do 63 budynków
Awaria ciepła na Ursynowie i Mokotowie. Kiedy ogrzewanie wróci do 63 budynków
W sobotni poranek mieszkańcy kilkudziesięciu budynków na pograniczu Ursynowa i Mokotowa obudzili się w wychłodzonych mieszkaniach. Od godziny 23:00 w piątek, 6 lutego, trwa szeroko zakrojona operacja techniczna mająca na celu usunięcie pilnej awarii...
newsnadzis.pl,
2026-02-07 20:11:04
2026-02-07 20:11:04

ewysmaz.pl
Zespół Pieśni i Tańca „Podlasie” z Szepietowa wraz z przedstawicielami lokalnych samorządów, gościł w Pałacu Prezydenckim w Warszawie. Wizyta była okazją do podkreślenia znaczenia regionalnego dziedzictwa kulturowego Podlasia oraz dorobku zespołu dzi...
ewysmaz.pl,
2026-02-07 20:10:10
2026-02-07 20:10:10

biznesinfo.pl
Punkty karne za korzystanie z nawigacji. W tym wypadku nie ma taryfy ulgowej
Punkty karne za korzystanie z nawigacji. W tym wypadku nie ma taryfy ulgowej
Codzienny nawyk, pozornie niewinny gest i rutyna, która okazuje się kosztowna. Dlaczego służby biją na alarm i co tak naprawdę jest dziś największym problemem na drogach? Nowoczesne samochody coraz częściej przypominają mobilne centra dowodzenia. Ekr...
biznesinfo.pl,
2026-02-07 20:10:08
2026-02-07 20:10:08

lowcygier.pl
Pudełkowe wydanie The Last Faith na PS5 już za 69 zł na Allegro
Pudełkowe wydanie The Last Faith na PS5 już za 69 zł na Allegro
Fani gier z gatunku metroidvania mogą zainteresować się ofertą na jedną z ciekawszych produkcji tego typu ostatnich lat. Fizyczną wersję gry The Last Faith, inspirowanej takimi tytułami, jak Castlevania czy Bloodborne, na konsolę PlayStation 5, kupic...
lowcygier.pl,
2026-02-07 20:09:09
2026-02-07 20:09:09

interia.pl
Papugarnia pokazała zdjęcia. Papuga zginęła z winy zwiedzających
Papugarnia pokazała zdjęcia. Papuga zginęła z winy zwiedzających
Papugarnia z ul. Marywilskiej w Warszawie przekazała, że nie żyje jeden z ptaków, który zamieszkiwał w tym miejscu. Powód śmierci jest nietypowy - w żołądku ptaka znaleziono metalowy element, który prawdopodobnie pochodził od któregoś z gości. Właści...
interia.pl,
2026-02-07 20:09:04
2026-02-07 20:09:04

comparic.pl
Więcej ofert, mniej kupujących. Styczeń odsłania słabość rynku nieruchomości
Więcej ofert, mniej kupujących. Styczeń odsłania słabość rynku nieruchomości
Początek roku na rynku wtórnym mieszkań rządzi się swoimi prawami. Styczeń tradycyjnie przynosi spadek liczby transakcji, ale jednocześnie to właśnie wtedy zauważalnie rośnie liczba ofert sprzedaży. W 2026 roku ten schemat ponownie się potwierdził, c...
comparic.pl,
2026-02-07 20:08:17
2026-02-07 20:08:17

imagazine.pl
Koniec domysłów. Sony WF-1000XM6 nadchodzą 12 lutego. Teaser potwierdza nowy kształt
Koniec domysłów. Sony WF-1000XM6 nadchodzą 12 lutego. Teaser potwierdza nowy kształt
Sony oficjalnie przerywa milczenie. Po serii nieoficjalnych grafik, japoński gigant potwierdził datę premiery nowej generacji swoich flagowych słuchawek. Krótki, mroczny klip zdradza też, że czeka nas spora rewolucja w designie. W wideo opublikowanym...
imagazine.pl,
2026-02-07 20:08:07
2026-02-07 20:08:07
topagrar.pl
Groźne grzyby mogą być ukryte w nasionach soi! Osłabione wschody i plonowanie
Groźne grzyby mogą być ukryte w nasionach soi! Osłabione wschody i plonowanie
Soja przez lata uchodziła za uprawę stosunkowo bezpieczną pod względem chorób. Jednak ostatnie sezony pokazują, że sytuacja zaczyna się zmieniać, a problem może pojawiać się już na etapie siewu. Coraz częściej w materiale siewnym wykrywa się patogeny...
topagrar.pl,
2026-02-07 20:07:09
2026-02-07 20:07:09

radiopik.pl
W Radłówku i Inowrocławiu upamiętniono 42. rocznicę śmierci Piotra Bartoszcze
W Radłówku i Inowrocławiu upamiętniono 42. rocznicę śmierci Piotra Bartoszcze
Działacz opozycji antykomunistycznej i przywódcy NSZZ „Solidarność” Rolników Indywidualnych zginął prawdopodobnie z rąk Służby Bezpieczeństwa w nocy z 7 na 8 lutego 1984 roku.Wiązanki kwiatów pod jego pomnikiem złożyli w sobotę (7.02.) przedstawiciel...
radiopik.pl,
2026-02-07 20:06:06
2026-02-07 20:06:06

focus.pl
W egipskim klasztorze znaleźli 1300-letni rękopis. Zawiera informacje o początkach wielkiej religii
W egipskim klasztorze znaleźli 1300-letni rękopis. Zawiera informacje o początkach wielkiej religii
W jednym z najstarszych klasztorów świata, na egipskim Synaju, przeleżał całe stulecia niepozorny rękopis. Jego pożółkłe, miejscami sklejone strony i późniejsze, XIII-wieczne pismo po arabsku nie wzbudzały większego zainteresowania. Wyglądał na kolej...
focus.pl,
2026-02-07 20:06:04
2026-02-07 20:06:04

wiadomosci.wp.pl
Atak na Ukrainę, olimpijskie emocje i mandat Żurka
Atak na Ukrainę, olimpijskie emocje i mandat Żurka
Sobota rozpoczęła się masowym ostrzałem Ukrainy przez Rosję, w wyniku którego w powietrze znów wzbiły się polskie i sojusznicze myśliwce, a lotniska w Rzeszowie i Lublinie czasowo wstrzymały operacje. Dziś także okazało się, że minister Waldemar Żure...
wiadomosci.wp.pl,
2026-02-07 20:05:16
2026-02-07 20:05:16

elektromobilni.pl
Państwo zakazało driftu, ale zapomniało o punktach karnych. MSWiA zapomniało o rozporządzeniu
Państwo zakazało driftu, ale zapomniało o punktach karnych. MSWiA zapomniało o rozporządzeniu
Nowe przepisy weszły w życie 29 stycznia 2026 roku wraz z nowelizacją Kodeksu wykroczeń, która miała zaostrzyć odpowiedzialność tzw. piratów drogowych. Wśród nowych czynów zabronionych znalazło się m.in. celowe wprowadzanie pojazdu mechanicznego w po...
elektromobilni.pl,
2026-02-07 20:05:14
2026-02-07 20:05:14

ppe.pl
Prawnik z Lincolna (2022) - recenzja serialu . Mickey Haller wrobiony
Prawnik z Lincolna (2022) - recenzja serialu . Mickey Haller wrobiony
W bagażniku prawnika z Lincolna znalezione zostaje ciało jego byłego klienta. Zostaje wsadzony do aresztu, gdzie prócz szykowania obrony w sądzie, będzie musiał też zająć się obroną swoich czterech liter, zanim ktoś go zasztyletuje czy pomo...
ppe.pl,
2026-02-07 20:04:24
2026-02-07 20:04:24

spidersweb.pl
Ciotka umarła, a nie miała dzieci. Kto dostanie jej majątek?
Ciotka umarła, a nie miała dzieci. Kto dostanie jej majątek?
Ciotka umarła, a nie miała dzieci. Kto dostanie jej majątek?
spidersweb.pl,
2026-02-07 20:04:14
2026-02-07 20:04:14

interia.pl
Vance wygwizdany w Mediolanie. Biały Dom reaguje i manipuluje nagraniem
Vance wygwizdany w Mediolanie. Biały Dom reaguje i manipuluje nagraniem
Wiceprezydent USA J.D. Vance i jego małżonka zostali wygwizdani podczas piątkowej ceremonii otwarcia Zimowych Igrzysk Olimpijskich w Mediolanie. Publikujący z tego wydarzenia nagranie Biały Dom zmanipulował jego treść, usuwając dźwięki dezaprobaty i...
interia.pl,
2026-02-07 20:03:10
2026-02-07 20:03:10

gram.pl
Roblox to jedna najpopularniejszych wśród dzieci produkcji. Niemniej nie wszystkim dane jest obcować z dziełem Roblox Corporation.
gram.pl,
2026-02-07 20:03:09
2026-02-07 20:03:09